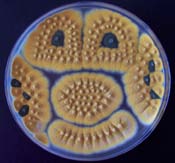
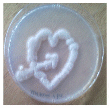
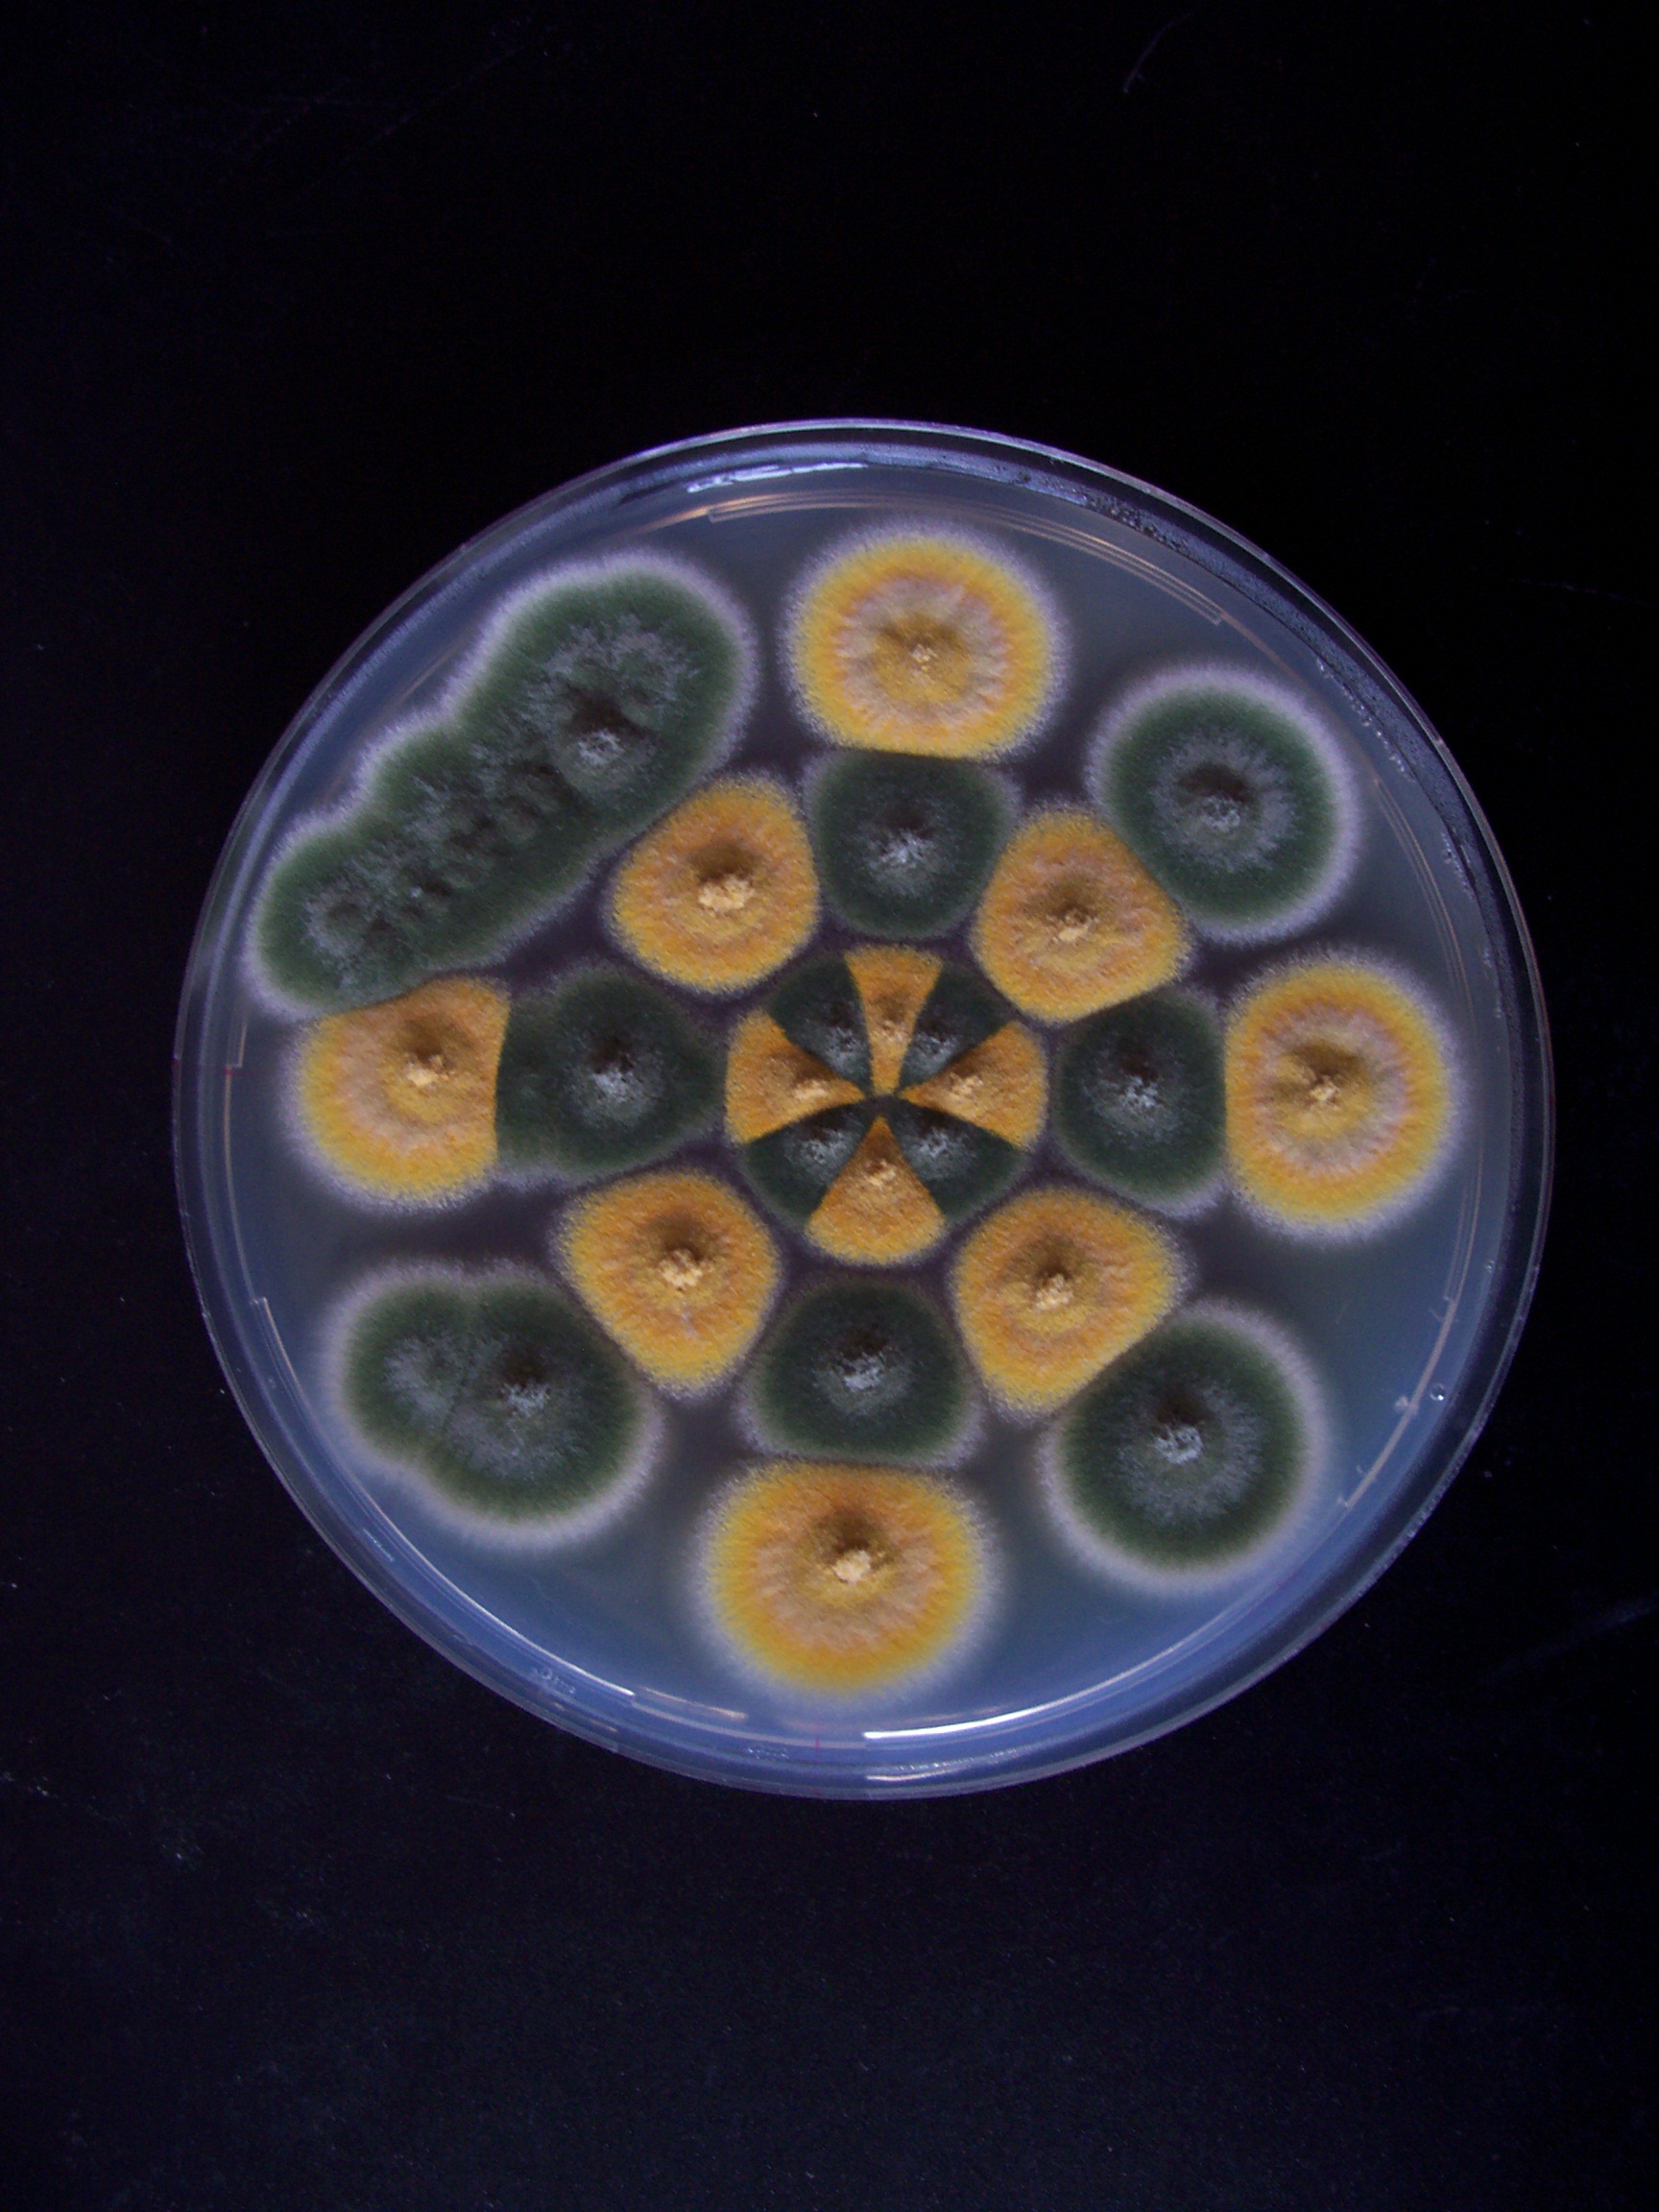

Director of Research
Head of the Microbial Molecular Genetics Laboratory
Dr. Vicky Sophianopoulou
vickybio.demokritos.gr
(+30) 2106503563 -3602
Fax (+30) 2106511767
Research Staff
Christos Gournas: Researcher
Ada Biratsi, Post-Graduate Fellow (PhD candidate)
Mirsini Charicleous, Undergraduate Student (Diploma Thesis)
Loudres Arias Salazar, Erasmus student
Research Interests
Our group is primarily interested in several aspects concerning: 1) regulation of expression, structure-function relationships, specificity, cell biology and evolution of amino acid transporter proteins and 2) the lateral organization of the fungal plasma membrane. Our model organism of choice is the non-pathogenic ascomycetes Aspergillus nidulans, a classic model genetic system since the 1950's. Two A. nidulans amino acid transporters have been cloned and studied in detail in respect to their transcriptional, post-translational/functional and cellular control of expression. In addition, we have introduced A. nidulans as a novel model system for the expression and/or functional characterization of heterologous transporter genes (Argyrou et al. 2001). In parallel, the last 7 years we have been studying the lateral compartmentation of A. nidulans plasma membrane and how this organization is implicated in different cellular processes. In particular we are focusing on “eisosomes” static plasma membrane compartments that constitute nanoscale furrow-like invaginations of the plasma membrane, where proteins and lipids segregate and their implication in fundamental cellular processes (sphingolipid biosynthesis, endocytosis of membrane proteins, function of efflux pumps and fungal pathogenicity).

Aspergillus nidulans.
A. Transporters of medical, pharmacological and agricultural importance
Study of APC transporters: Proline (PrnB) and glutamate/aspartate (AgtA) of Aspergillus nidulans
Transporters are transmembrane proteins mediating the translocation of solutes, metabolites and drugs across cell membranes, a biological process involved in nutrition, signaling, neurotransmission and cell communication. Despite their importance, the mechanism of transport function and specificity is very little known, due to the difficulties in obtaining X-ray diffraction-quality crystals and in applying NMR methods for the study of polytopic membrane proteins.
An alternative approach to understand structure-function relationships of transporters and channels is through functional analysis of mutated or molecularly modified versions of these proteins in easily manipulated systems. The work of R. Kaback and his group with the LacY lactose permease of Escherichia coli constitutes a unique paradigm. In this case, solely through the analysis of mutations, biochemical and biophysical approaches and the development of Cys-scanning mutagenesis, a model was proposed on how a transporter works, even before the eventual crystallization of LacY (Sorgen et al., 2002, Biochemistry; Guan L. and Kaback HR. 2006, Annu Rev Biophys Biomol Struct; Abramson et al. 2003, Science).
The contribution of our lab in structure-function analysis of transporters, concerns the use of mostly classical and reverse genetics, in vitro directed mutagenesis, Cys-scanning mutagenesis, molecular modeling, molecular dynamics and induced-fit docking studies to understand how the main proline transporter PrnB of A. nidulans (Tavoularis et al. 2001. 2003; Kafasla et al. 2007; Vangelatos et al. 2009, Gournas et al. 2015) or the glutamate/aspartate (AgtA) (A. Apostolaki et al. 2009) transporters, recognize and transport their substrates. Both proteins are members of the YAT (Yeast Amino acid Transporters) family belonging to the APC (Amino acid-Polyamine-organoCation) superfamily. In the case of PrnB, using a sensitive homology threading approach, molecular modeling, induced fit docking and classical and reverse genetics we showed that the predicted structure of APC members is extremely similar to the crystal structures of several prokaryotic transporters belonging to evolutionary distinct protein families with different substrate. All these proteins, despite having no primary amino acid sequence similarity, share a similar structural core, consisting of two V-shaped domains of five transmembrane domains each, intertwined in an antiparallel topology. Our analyses provide compelling evidence that the amino acid binding pocket is located in the vicinity of the unwound part of two broken helices of TMS1 and TMS6 and that the specificity is determined by: 1) variable residues forming a middle gate 2) variable residues between the middle and a distal gate and 3) variable residues of TMS6 and the unwound part of TMS6. These residues appear to determine specificity by directly interacting with the substrate, imposing steric constrains and/or affecting the local flexibility. In addition, our analyses present data on which amino acid residues are key elements for the stability and the trafficking of the amino acid transporters to the plasma membrane (Vangelatos et al. 2009; Gournas et al. 2015). Moreover, we have determined three trans-factors, an ER-chaperon, an enzyme of carbon catabolism and a casein kinase I, which affect trafficking and consequently the function of both PrnB and AgtA transporters (Erpapazoglou et al., 2006; Roumelioti et al. 2009; Apostolaki et al. 2012). The diverse function of these proteins indicates that fungal amino acid transporters are tightly regulated at a post translational level. In addition, our group is participating in a project concerning transporter evolution in Aspergilli (de Vries et al. 2017)|
|
|
|
An endoplasmic reticulum protein (ShrA), an enzyme of carbon metabolism (FbaA) and a casein kinase I (CkiA) are involved in internalization/endocytosis of two APC transporters; PrnB (proline transporter) and AgtA (dicarboxylic amino acid transporter) in Aspergillus nidulans |
ShrA is an endoplasmic reticulum (ER) protein marker in Aspergillus nidulans |

A. Predicted 3D structure of PrnB modeled on the inward-facing occluded crystal structure of LeuT (http://blanco.biomol.uci.edu/Membrane_Proteins_xtal.html; 2A65/3F3A). Left: Ribbon representation of the LeuT Leucine transporter from Aquifex aeolicus (RCSB entry: 2A65, solved at 1,65 A).Middle: The predicted 3D structure of PrnB. Right: the PrnB model superimposed with its LeuT template. The LeuT template is in red, whereas the PrnB model is in green colour.235x82mm (300 x 300 DPI) 27

Β. Schematic two-dimensional topology of PrnB in the plane of the membrane. The figure is based on the corresponding 3D model shown in Figure 1. Amino acid residues important for substrate binding in TMD1, TMD3, TMD6 and TMD8 are shown.

Left: Interactions of APCs with amino acid substrates: the PrnB paradigm. Super-imposition of the LeuT (red line) and PrnB (green line) structures and predicted interactions with proline. Right: Substrate interacting residues are shown in sticks representation for LeuT and ball and sticks representation for PrnB. Residues taken from the X-ray structure of LeuT (rcsb code: 2A65) are underlined.

Proline trajectory in PrnB (A) and Put4p (B)
B Plasma membrane organization and eisosomal proteins
Lipid rafts -membrane microdomains- in mammalian cells are regions important for membrane trafficking. In Saccharomyces cerevisiae, the existence of such subdomains was supported by the “patchy” distribution of transmembrane proteins, which led to the identification of the MCC (Membrane Compartment of Can1 (arginine/proton symporter)) (Walther et al. 2006; Moreira et al. 2009; Douglas et al. 2011). MCC colocalizes with eisosomes, punctate structures underlying the fungal cell membrane (subcortical structures) (Strádalová et al. 2009; Douglas et al. 2011). Eisosome structural assembly is dependent on the phylogenetically related cytosolic proteins Pil1p and Lsp1p and on sphingolipid levels, through regulation of Nce102p, Pkh1/2p and Ypk1p proteins (Olivera-Couto and Aguilar 2012). Eisosomes result in furrow-like invaginations of the plasma membrane due to a conserved BAR-domain present in their cytosolic proteins (Strádalová et al. 2009). Eisosomal specific proteins are exclusive of the dicarya, they are found in all ascomycetes and probably also in all basidiomycetes (Scazzocchio et al., 2011; Scazzocchio and Sophianopoulou unpublished). Importantly, in spite their striking lineage conservation, the function of eisosomal proteins concerning regulation of endocytosis, sphingolipid signaling, cell wall synthesis, plasma membrane organization and cell cycle progression remains elusive. Deletions of the cognate eisosomal genes resulted in mild and varied phenotypes in different species.
The contribution of our lab in this direction concerns the identification and cloning of GFP-tagged and knocked-out homologues of eisosomal proteins (core: PilA, PilB, SurG and Nce102) in the filamentous Pezizomycotina A. nidulans. In this fungus, in contrast to the Saccharomycotina, the fate of the core eisosomal proteins is developmentally regulated, having a complete different distribution in mycelia and spores (both conidiospores and ascospores) and being absent from hülle cells (Vangelatos et al. 2010, Scazzocchio et al. 2011, Athanasopoulos et al. 2013). PilA is a BAR-domain protein (P. Geranios, 2014, MA thesis) and the A. nidulans orthologue of Nce102p is member of a family of integral membrane proteins containing the MARVEL (MAL and related proteins for vesicle trafficking and membrane link) domain, conserved in fungi and animals, including humans. AnNce102 plays a crucial role in PilA localization and in the stability/number of PilA/SurG foci in the head of germlings generating from conidiospores. In addition, like PilA, AnNce102 genetically interacts with YpkA kinase of TORC2 and negatively regulates sphingolipid biosynthesis (A. Athanasopoulos et al. 2015). Moreover, YpkA kinase repression mimics genetic or pharmacological depletion of sphingolipids, conditions that induce the production of Reactive Oxygen Species (ROS) and can be partially overcome by deletion of pilA and/or annce102 at high temperatures. Consistent with these findings, evidence is provided that pilAΔ and Annce102Δ show differential sensitivity to various oxidative agents, while AnNce102 overexpression can bypass sphingolipid depletion regarding the PilA/SurG foci number and organization, also leading to the ectopic localization of PilA to septa (Athanasopoulos et al. 2015)..|
A. |
|
|
|
|
|
B. |
|
|
Eisosomal proteins in conidiospores and ascospores of Aspergillus nidulans |
|
C. Amino acid toxic analogue detoxification mechanisms
L-Azetidine-2-carboxylic acid (AZC) is a toxic analogue of proline produced by members of the Liliaceae family and beat roots. In nature, AZC serves as a plant protectant against infections and consumption. We have obtained evidence that AZC is not only non-toxic for the model ascomycete A. nidulans, but it can be utilized as a poor nitrogen source.
In this direction, the last 2 years, we are trying to elucidate the molecular mechanism underlying AZC detoxification in A. nidulans, by studying the cognate genes involved in AZC detoxification in Pseudomonas and Saccharomyces cerevisiae. These genes, found by in silico analysis, encode a putative hydrolase, achA, and an AZC acetyltransferase ngn2 (A. Biratsi et al. 2016. 34th SMYTE, Chania, Greece).
The principal current interest of the lab is to use A. nidulans as a model system for:
- Genetically and biochemically dissecting the structure-function relationships underlying topogenesis, function and specificity of amino acid transporter.
- Identifying metabolic pathways and elucidate the molecular mechanisms involved in trafficking, internalization/endocytosis of specific transporters in response to various physiological, developmental and genetic signals.
- Studying the role of eisosomal proteins in fungal membrane lateral organization in response to trafficking and endocytosis of specific transporters, sphingolipid signaling, oxidative stress, and animal/human infections.
We are currently asking the following questions
- How can we convert the specificity of PrnB and /or AgtA?
- Which residues/motifs are necessary for ER-exit, Golgi-exit and trafficking to the plasma membrane of PrnB?
- Which is the role of eisosomal and eisosomal-associated proteins (Nce102, Nce102-like, YpkA, Slm1/2 kinases etc.) in membrane organization and fundamental cellular processes?
- How L-Azetidine-2-carboxylic acid, a toxic analogue of proline, is detoxified and catabolized by A. nidulans.
PhD Theses:
S. Tavoularis (2002), Department of Biology, National University of Athens
E. Argyrou (2004), Department of Biology, National University of Athens
Z. Erpapazoglou (2006), Department of Biology, National University of Athens
Μ. Billini (2008), Department of Biology, National University of Athens
K. Roumelioti (2009), Department of Biology, National University of Athens
D. Bouzarelou (2010), Department of Biology, National University of Athens
A. Athanasopoulos (2015), Department of Biology, National University of Athens
A. Biratsi (in progress), Department of Biology, National University of Athens
Master Theses:
A Bobori (2007) Department of Biology, National University of Athens
P. Geranios (2014) Department of Biology, National University of Athens
Diploma Theses: 14
Erasmus: 2















